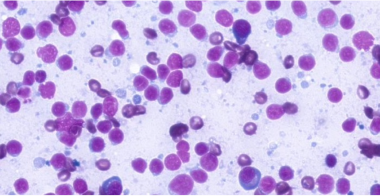
reactive-lymphoid

Reduce client anxiety with fast, in-clinic cytologic analysis
- AI powered analysis for results within minutes1,2
- Evaluates potentially cancerous cells in common lymph node and skin/subcutaneous masses
- Clear, detailed images for informed decisions
- Familiar slide preparation without changing your workflow
- Expert clinical pathologist review when clinically warranted†
- In-clinic screening for more accessible testing
Part of the complete, in-clinic cytologic solution
Efficient, reliable results
In-clinic screening of potentially cancerous cells in common lymph node and skin/subcutaneous masses with deep-learning AI enables fast, accurate1,2 diagnosis and treatment.
Optimal workflow
Familiar, one-time sample preparation and rapid results save time while allowing your clinic to maintain your current workflow.
Advanced patient care
Help improve compliance and reduce pet owner stress by providing accessible, in-clinic screening.
How it works
- Highly accurate1,2 analysis of common lymph node and skin/subcutaneous masses
- Identifies findings suggestive of large, medium, small or mixed lymphocyte population, inflammatory cells, plasma cells, reactive lymph node or neoplasia, histiocytoma, mast cell tumour, plasma cell tumour, large cell lymphoma, reactive lymphoid hyperplasia, lymph node with inflammation, not lymph node, lipoma/adipose tissue, keratin containing lesion or inflammation
- Fast, point-of-care screening unlocks individualized treatment for patients
Part of a comprehensive cytology offering
Unlock the freedom to make timely individualized diagnoses and treatment decisions that fit your patients’ needs with Vetscan Imagyst cytology.
High-resolution images for more confident diagnoses



Large cell lymphoma (neoplasia)



Lymph node with inflammation



Adipose or salivary tissue

Reactive lymphoid hyperplasia



Histiocytoma



Mast cell tumour



Plasma cell tumour



Lipoma/adipose tissue



Keratin containing lesion



Inflammatory lesion
Frequently Asked Questions
Both Vetscan Imagyst AI Masses and Digital Cytology can help you provide quick answers to anxious pet owners. AI Masses allows you to test common lymph node and skin/subcutaneous masses in-office for fast results in minutes. With Digital Cytology, you can send the samples to board-certified clinical pathologists for results delivered when you need them.‡,3
The types of clinical profiles that can be identified via AI Masses samples include:
Lymph node:
- Large cell lymphoma (neoplasia)
- Lymph node with inflammation
- Not lymph tissue (adipose or salivary tissue)
- Reactive lymphoid hyperplasia
- Indeterminate results
Subcutaneous masses:
- Histiocytoma
- Mast cell tumour
- Plasma cell tumour
- Lipoma/adipose tissue
- Keratin containing lesion
- Inflammatory lesion
- Indeterminate results
As with all Vetscan Imagyst applications, you'll need a laptop, tablet, or mobile device and a Vetscan Imagyst scanner. In addition, you’ll need standard materials including 25 x 75 mm microscope glass slides with frosted edge, Romanowsky-type stain (e.g. Diff Quik), immersion oil, 24 x 60 mm coverslips, a pencil and gloves.
AI Masses allows you to test common lymph node and skin/subcutaneous masses.
With the same familiar single-sample preparation, AI Masses doesn't require you to change your traditional workflow, giving you more time to focus on patient care.

Bringing specialist-level medicine to your clinic
The Zoetis Virtual Laboratory is an integrated support network of board-certified specialists paired with expert-level AI1,2 4-13, enhancing every element of your diagnostic practice to help you diagnose and treat with confidence.
- Deep-learning AI
- Anytime§ expert support
- Connected diagnostic insights

Explore the full Vetscan Imagyst portfolio
Small, mighty and picture perfect, Vetscan Imagyst delivers unmatched insights across six powerful testing capabilities.
Discover the difference Vetscan Imagyst can make in your clinic
Contact us today to learn more about how our diagnostics portfolio can help elevate your patient care.
Customer Service, Support & Ordering
Mon – Fri: 8:00 am – 16:30 pm EST
1-800-663-8888
Zoetis Reference Laboratories Customer Service, Support & Ordering
Mon – Fri: 8:00am – 9:30pm ET
Saturday: 9:00am – 8:30pm ET
Sunday: Closed
1-888-965-9652
Need Technical Support?
Our support team is available to answer product questions and provide guidance.||
24 hours a day, 7 days a week, 365 days a year
1-888-746-2395 (En/Fr)
AlphaTrak product support for pet owners
Mon – Thr : 9.00 am – 5.00 pm EST
Friday : 9.00 am – 1.00 pm EST
1-888-746-2395 (En/Fr)
Discover the difference Vetscan Imagyst can make in your clinic
Contact us today to learn more about how our diagnostics portfolio can help you elevate your patient care.
Customer Service, Support & Ordering
Mon – Fri: 8:00 am – 4:30 pm EST
1-800-663-8888
Zoetis Reference Laboratories Customer Service, Support & Ordering
Mon – Thurs: 8:00 am – 9:30 pm GMT
Saturday: 9:00am – 8:30pm GMT
Sunday: Closed
1-888-965-9652
Need Technical Support?
Our support team is available to answer product questions and provide guidance.||
1-888-746-2395 (En/Fr)
AlphaTrak product supports for pet owners
Mon – Thr : 9.00 am – 5.00 pm EST
Friday : 9.00 am – 1.00 pm EST
1-800-461-0917
* Vetscan Imagyst is the commercially available veterinary AI analyzer on the market offering seven microscopic testing capabilities.
† Option to send digital slide image to our network of clinical pathologists as needed. Additional costs apply.
‡ Additional costs may apply
§ Dependent on consultant availability.
|| If you are a pet owner looking for treatment recommendations, please contact your vet.
References: 1. Company data - Study No. DHX6Z-US-25-285, 2025. 2. Company data - Study No. DHX6Z-US-25-286, 2025. 3. Company data - Study No. TI-11711, 2024. 4. Company data - Study No. DHX6Z-US-23-205, 2024. 5. Company data - Study No. DHX6Z-US-23-206, 2024. 6. Company data - Study No. DHX6Z-US-23-209, 2024. 7. Company data - Study No. DHX6Z-US-24-257, 2024. 8. Company data - Study No. DHX6Z-US-24-242, 2024. 9. Company data - Study No. DHX6Z-US-24-275, 2024. 10. Company data - Study No. DHX6Z-US-24-276, 2024. 11. Company data - Study No. DHX6Z-US-23-222, 2023. 12. Company data - Study No. DHX6Z-US-22-131, 2022. 13. Company data - Study No. DHXMZ-US-24-235, 2024.